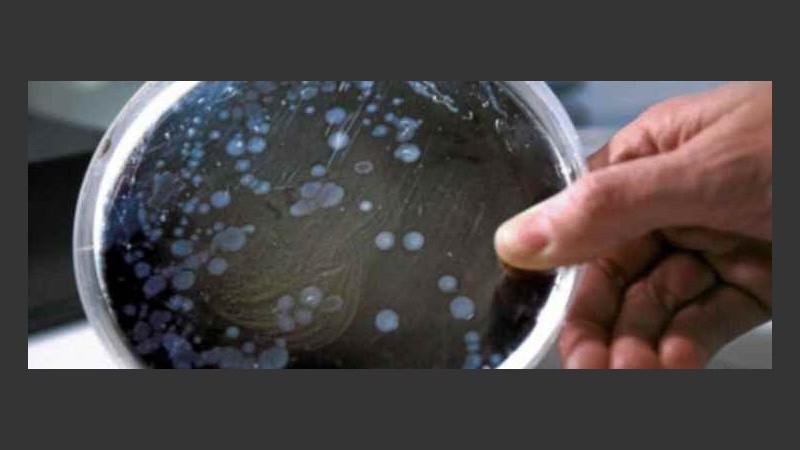
Sólo una de cada 33 mil personas contraen una infección de este tipo al año

Una rara bacteria carnívora comió, literalmente, las extremidades y parte de la cara de Alex Lewis, un británico de 34 años.
Según relata The Metro, el joven padre acudió al médico pensando que tenía un resfrío común. Sin embargo, una infección sanguínea lo dejó en coma una semana tras invadir sus órganos: pies, dedos, brazos, labios y la nariz.
El medio inglés explica que Lewis "contrajo una infección por estreptococo que se convirtió en septicemia y derivó en síndrome del choque tóxico" (TSS por sus siglas en inglés).
Alex, quien es originario de Stockbridge, Hampshire, aseguró que el inmenso dolor de sus lesiones no es comparable al que siente cuando su pequeño hijo de 3 años de edad se niega a estar cerca de él por su aspecto.
Sólo una de cada 33 mil personas contraen una infección de este tipo al año, por lo general pueden ser tratadas con antibióticos.
A pesar de todo, Alex señaló que tiene "suerte de estar vivo" y que nada le impedirá seguir adelante con su vida y proyectos
Según explicó Lewis, cuando fue diagnosticado, los médicos le indicaron que tenía "apenas un tres por ciento de probabilidad de sobrevivir".